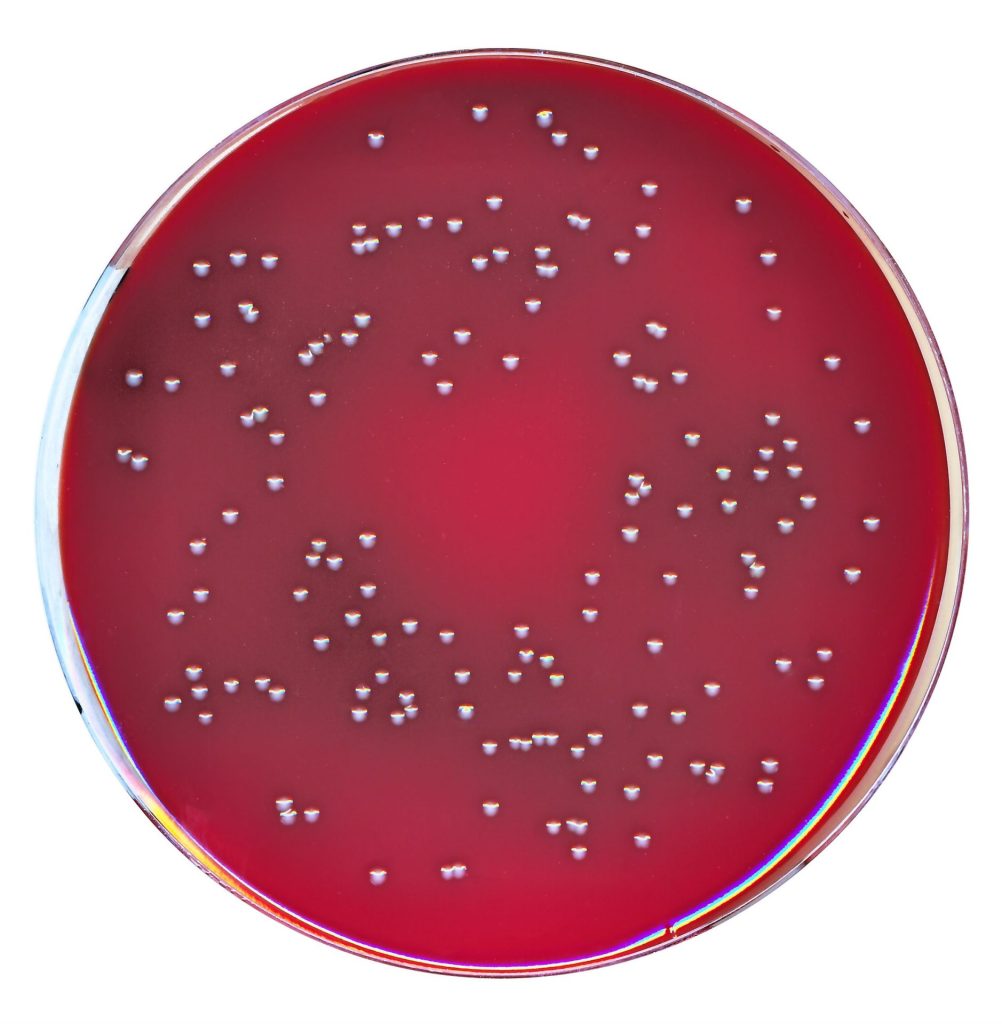

ie
Description: Fastidious Anaerobic Agar + NEO + NAL a primary isolation medium capable of growing most clinically significant anaerobes.
Catalogue No: W11320
Product Type: 90mm Petri Dish
Unit Size: 10
Storage Temp: 2-10°C
pH Value: 7.2 +/- 0.2
Growth Promotion:
Bacteroides Fragilis ATCC® 25285 Growth
Proteus Mirabilis ATCC® 29906 Inhibition
N.B. Some products may be subject to minimum order quantity